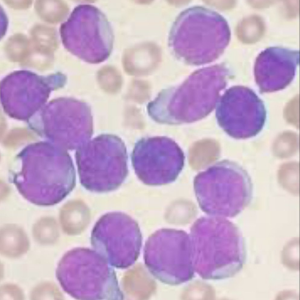

Tem alguma dúvida?
Clica no botão abaixo e fala com a gente pelo WhatsApp

Identificar, descrever e liberar os laudos de Hemograma com os achados morfológicos presentes nas Leucemias Agudas (LMA. LLA, LPA, LPAv e Monoblástica), Leucemias Crônicas (LMC e LLC), outras Neoplasias Hematológicas (Mielofibrose, Trombocitemia Essencial, Policitemia Vera, Tricoleucemia), Mieloma e Linfomas, como:

Medula óssea visão geral
-Medula óssea uma visal geral
-Proeritroblastos, eritroblastos medulares
-Megacariócitos, Macrófagos
-Blastos
-Leucemia mieloide aguda
-Mieloblastos, Bastonetes de Auer
-Grânulos azurõfilos e blebls
-Leucemia linfoblastica aguda
-Blastos linfoides
-Leucemia promielocitica aguda
-Promielócitos hipergranulares e hipogranulares
-Leucemia monoblástica e monocítica
-Monoblasto, promonócitos e monocítos
-Sangue periférico
-Medula óssea
-Hemograma nas leucemias agudas

- Alterações medulares na síndrome mielodisplasicas
- Displasias Eritróides
- Pontes citoplasmaticas e nucleares
- Micromegacariositos
- Pseudo Pelger Huet
- Alterações Hematologicas nas sindormes mielodisplasicas

- Neoplasias Mieloproliferativas
- Granulocitos imaturos
- Basófilos
- Desvio a esquerda escalonado: segmenatdos a blastos
- Leucemia mieloide crônica sangue periférico
- Leucemia mieloide cronica na fase cronica
- Leucemia mieloide cronica na fase blastica
- Medula ossea na leucemia mieloide cronica
- Mielofribrose primária
- Alterações hematologicas e morfológicas
- Reação leucoeritroblastica
- Trombocitemia essencial
- Achados periféricos em hemogramas e laminas com mais de 1 milhão de plaquetas
- PTI - Purpura trombocitopenica imunologica
- Achados medulares
- Hipercelularidade meriogacariocitica
- Plaquetopenia no sangue periferico
- Leucemia linfocitica crônica
- Sombras nucleares de gumprecht: como relatar no hemograma e a morfologia na LLC
- Leucemia prolinfocitica
- Tricoleucemia: morfologia e hemograma,
- Mielolama múltiplo
- Plasmócitos displacicos na medula óssea
- Hemacias em Rouleaux nos mieloma e na leucemia de celulas plasmáticas

- Linfomas periféricos
- Linfoma do manto
- Lingoma folicular
- Linfoma esplêncio da zona marginal
- Linfoma de Burkitt
- Síndrome de sézary

-Medula óssea uma visal geral
-Proeritroblastos, eritroblastos medulares
-Megacariócitos, Macrófagos
-Blastos
-Leucemia mieloide aguda
-Mieloblastos, Bastonetes de Auer
-Grânulos azurõfilos e blebls
-Leucemia linfoblastica aguda
-Blastos linfoides
-Leucemia promielocitica aguda
-Promielócitos hipergranulares e hipogranulares
-Leucemia monoblástica e monocítica
-Monoblasto, promonócitos e monocítos
-Sangue periférico
-Medula óssea
-Hemograma nas leucemias agudas

- Alterações medulares na síndrome mielodisplasicas
- Displasias Eritróides
- Pontes citoplasmaticas e nucleares
- Micromegacariositos
- Pseudo Pelger Huet
- Alterações Hematologicas nas sindormes mielodisplasicas
- Neoplasias Mieloproliferativas
- Granulocitos imaturos
- Basófilos
- Desvio a esquerda escalonado: segmenatdos a blastos
- Leucemia mieloide crônica sangue periférico
- Leucemia mieloide cronica na fase cronica
- Leucemia mieloide cronica na fase blastica
- Medula ossea na leucemia mieloide cronica
- Mielofribrose primária
- Alterações hematologicas e morfológicas
- Reação leucoeritroblastica
- Trombocitemia essencial
- Achados periféricos em hemogramas e laminas com mais de 1 milhão de plaquetas
- PTI - Purpura trombocitopenica imunologica
- Achados medulares
- Hipercelularidade meriogacariocitica
- Plaquetopenia no sangue periferico
- Leucemia linfocitica crônica
- Sombras nucleares de gumprecht: como relatar no hemograma e a morfologia na LLC
- Leucemia prolinfocitica
- Tricoleucemia: morfologia e hemograma,
- Mielolama múltiplo
- Plasmócitos displacicos na medula óssea
- Hemacias em Rouleaux nos mieloma e na leucemia de celulas plasmáticas

- Linfomas periféricos
- Linfoma do manto
- Lingoma folicular
- Linfoma esplêncio da zona marginal
- Linfoma de Burkitt
- Síndrome de sézary

- 5 Aulas explicando o hemograma na Leucemia Mieloide aguda
- Hemograma na Leucemia Linfoblastica aguda
- Hemograma Na LPA clássica e variante
- Hemograma e morfologia da mielodisplasia, anemia, plaquetopenia e achados de insuficiencia medular em idosos
- Hemograma na Leucemia mieloide cronica, na mielofribose e a tromnositemia essencial
- Hemograma nas Leucemias linfoides cronicas, nos linfomas e mielomas
- Como e relatar e liberar todos os hemogramas






– Aula Online e Ao Vivo
segunda-feira
– 19:30 às 22h
– Aula Online e Ao Vivo
segunda-feira
– 19:30 às 22h
– Aula Online e Ao Vivo
segunda-feira
– 19:30 às 22h
– Aula Online e Ao Vivo
segunda-feira
– 19:30 às 22h

fundada em 2019 pelo Prof. Dr. Luiz Arthur Calheiros Leite, a Escola Brasileira de Hematologia Laboratorial (LaHemato EaD) já compartilhou conhecimento com mais de 5.000 alunos do Brasil e exterior, em mais de 10 diferentes cursos da área laboratorial.